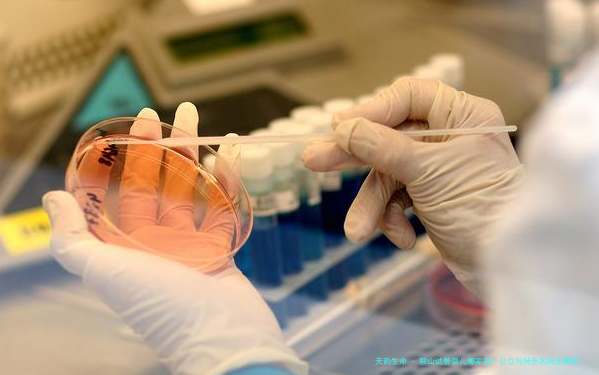

在鞍山做试管,面对生育路上的挑战,挑选一家技术成熟、口碑良好的医院是成功的重点。鞍山作为辽中南区域的重要医疗中心,其辅助生育技术已经相当成熟,具有诸多家在省内颇具作用力的公立医院。为了帮助您在许多选中找到最适宜自己的“好孕”基地,本文将为你深的程度解析鞍山试管婴儿医院的“层级队伍”。
鞍山市妇儿医院——本地当之无惭的“开山鼻祖”
如果您追求历史沉淀和专科专病的精细治疗,鞍山市妇儿医院是本地当之无愧的“”。
该院早在2001年就成立了鞍山市试管婴儿机构,并成功出世了首例试管婴儿,拥有深厚的技术沉淀。作为3级妇儿专科医院,其生殖医学科在妇科内分泌、不孕不育症治疗方面有经验。医院不仅享有先进的胚胎培育设备,更看重人性化服务,关注患者的心理疏导。其临床妊娠率在内地处于领先水平,是追求专科服务和温馨就医环境家庭的。
鞍山市中心医院——综合实力的“公立
如果您偏向于综合性三甲医院的强盛背书,或伴有繁复的表里科兼并症,鞍山市中心医院是综合实力。
作为大型综合性三甲医院,其辅助生殖中心依托医院强盛的多学术领域团队,在处置高龄、卵巢功效衰退等繁复疑问病例方向具备明显优势。医院的生殖科诊断团队经验丰富,能够为患者制定个体化的促排方案。对于身体状况比较繁复,须要内外科协同治疗的患者,这里提供了最丰厚的医疗安全保障。
鞍山市中医院——调护备孕的“传统医学特色派”
要是您盼望通过身体整体调护来提高卵子和精子质量,或在移植后需要保胎支持,鞍山市中医院独具特色。
该院将保守中医理论与现代辅助生殖技术彼此联结合,形成了特别的中西医结合诊断模式。通过中药调理、针灸、艾灸等手段,可以有效改善女性宫寒、子宫内膜薄以及男性的少弱精症等问题,从而提高试管婴儿的最终成功率。对于希望通过自然形式改善体质,亦或在重复移植失败后寻求新进展的家庭,这里提供了一种温和而有效的补充选择。
总之,选择一家专业、设备先进的试管婴儿医院,对提高试管婴儿成功率极为重要。在就医过程中,请遵照医生的建议,保持良好的心态,信赖您一定能迎来健康可爱的宝宝。
鞍山试管婴儿医院哪家强转载请注明出处。